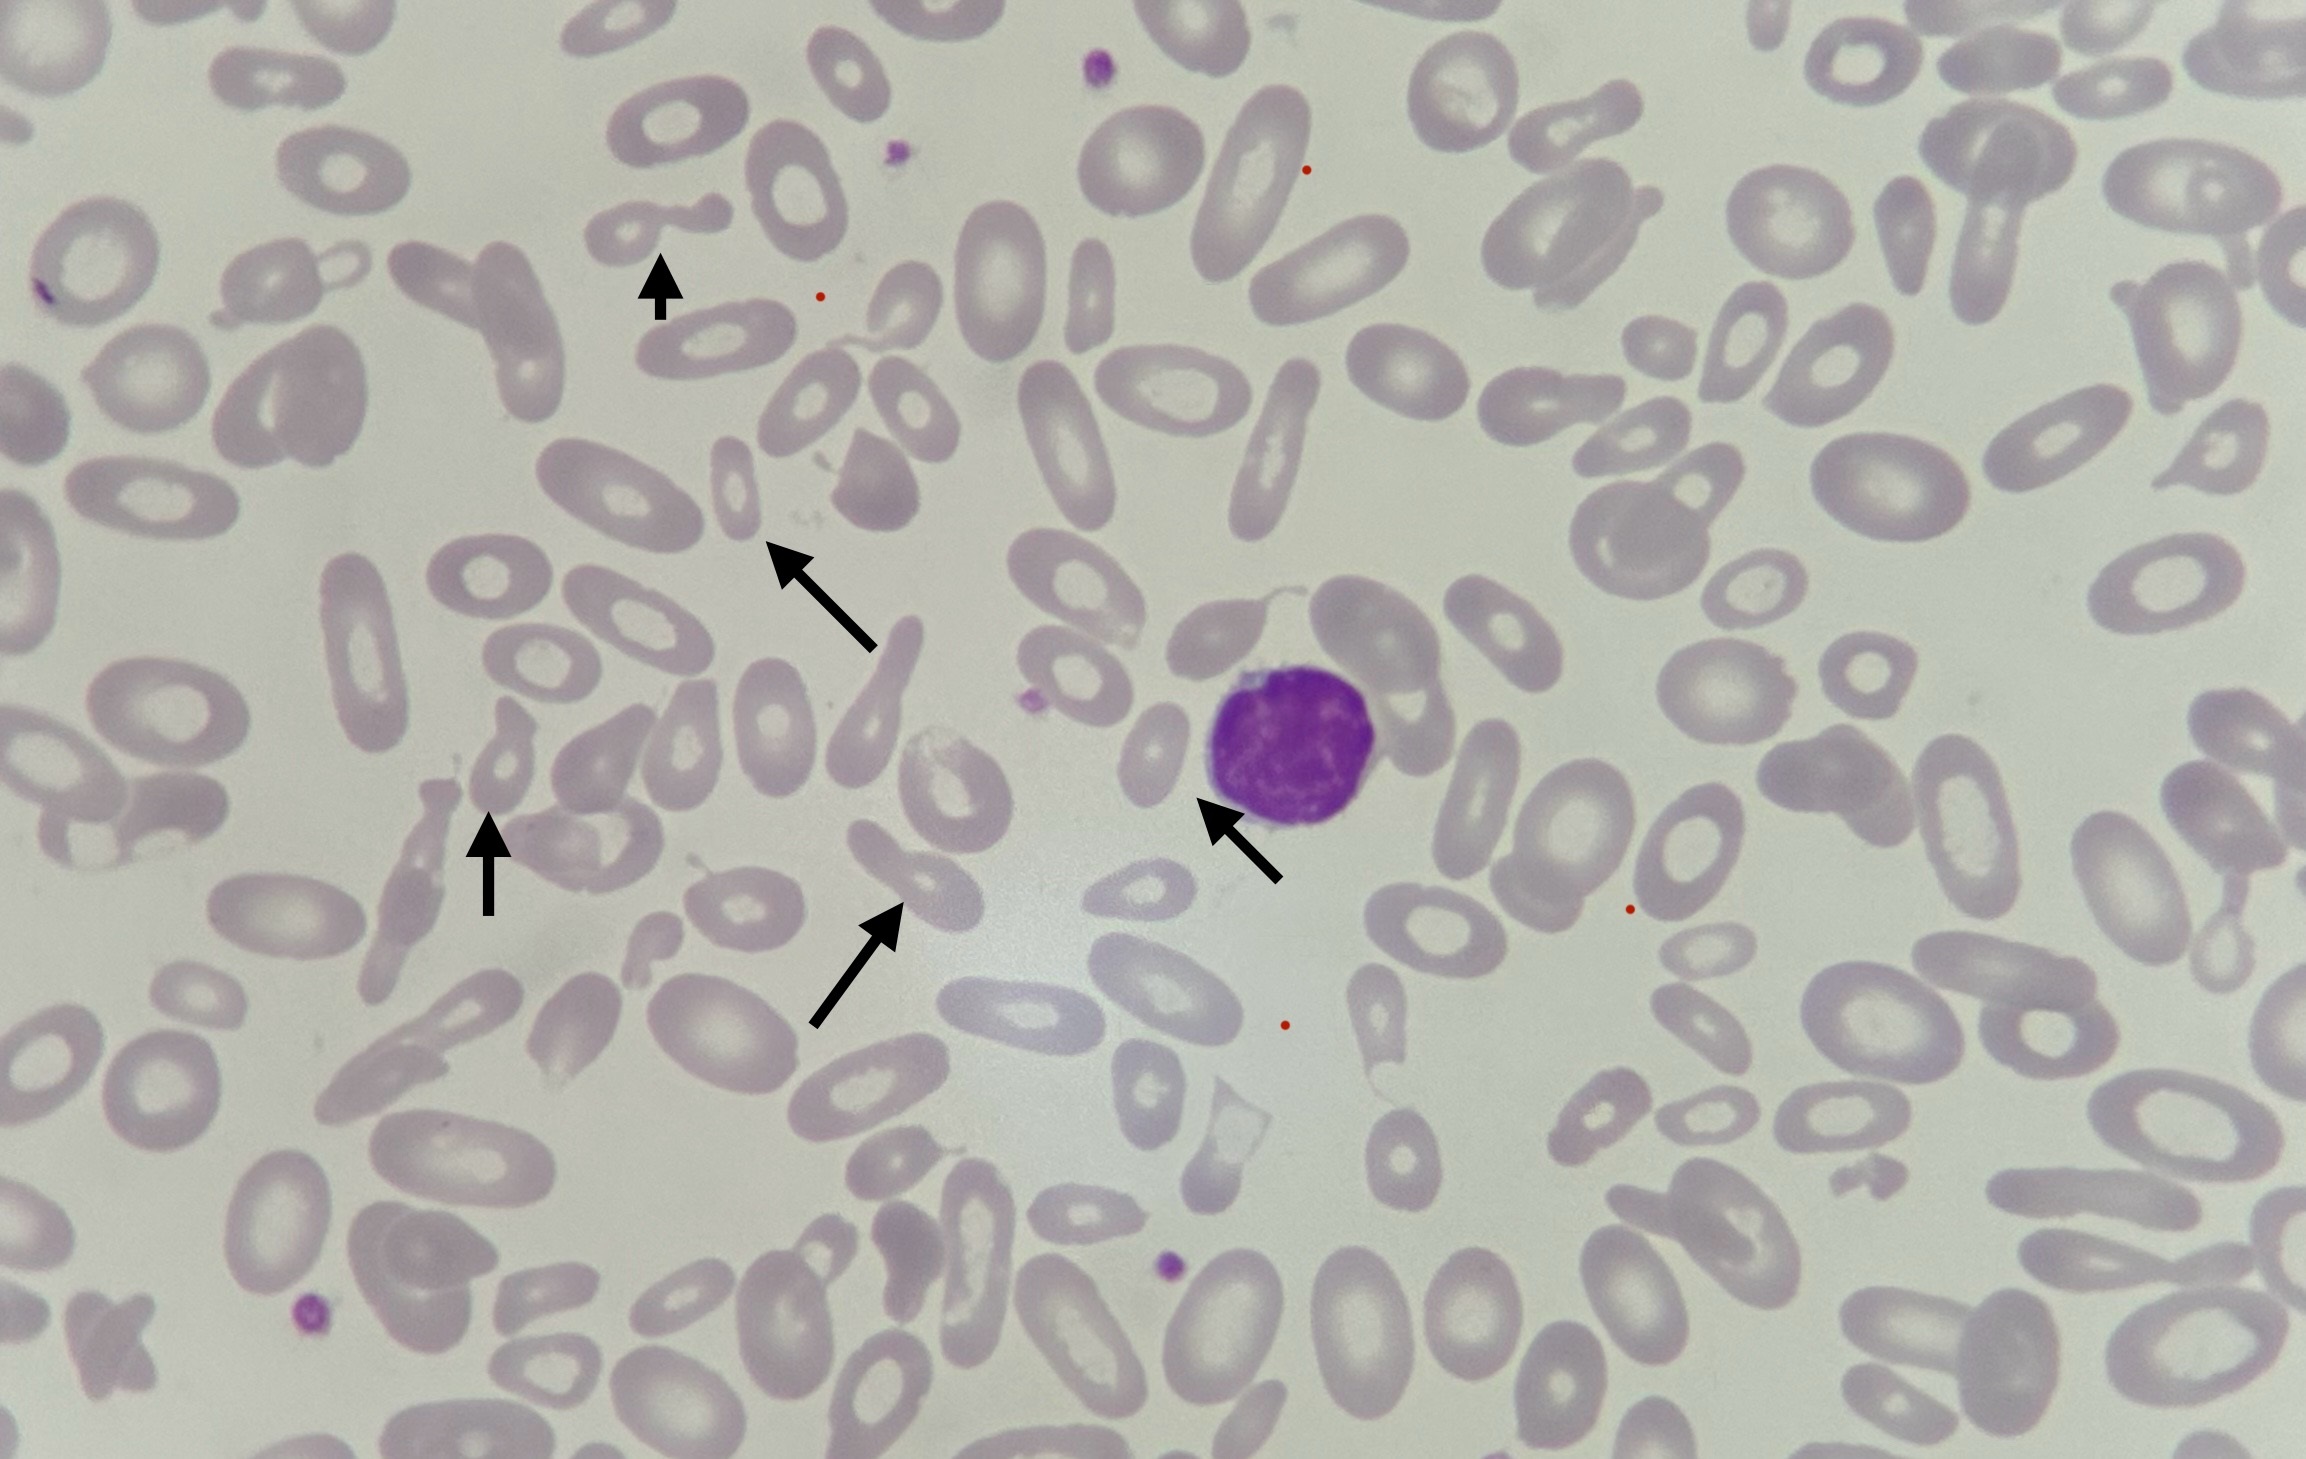

Эритроциты 6 скорость
Эритроциты 6 скорость 104 фото
Стеллаж 12 см
Вологда великий новгород расстояние на машине
Англ яз стр 97 номер 7
Техосмотр перед регистрацией
Решу впр физика 7 класс 10 задание
Мультикан 8 как делать
Прием без прививки
Как получить консоль в кс го
Стандартные размеры правил
Бах хтк 2 том слушать